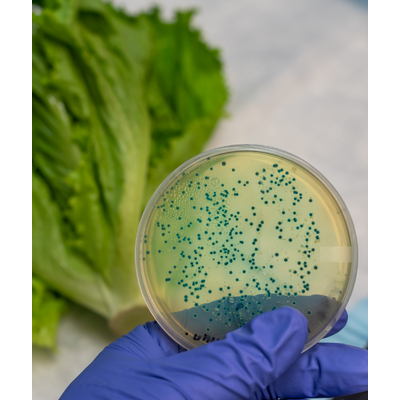

- Home
- Companies
- SmartFoodSafe
- Software
SmartFoodSafe software
Smart - Quality and Food Safety Audit Management Software
Replace traditional audit checklists with powerful digital applications to automate audit processes and improve compliance gaps.
Smart CAPA - Corrective and Preventive Action (CAPA) Management Software
Effective management of complaints, holds and deviations through root cause analysis to corrective and preventive action planning and implementation.
Smart - Automated Product Release and Compliance Management Software
Streamline product release processes with automated verification of specification and improve product compliance in real time.
Smart - Digital Document Management Features
Cost-effective and digital document compliance to global quality and food safety management systems.
/Smart - Automate Environmental Monitoring with EMP Software
Transform environmental monitoring digitally to achieve fully automated mapping, scheduling, and pre-defined corrective actions in maintaining a safe and hygienic environment.
Smart HACCP - Food Safety Management Software
Automate and manage food safety hazards, identify critical control points (CCP) or preventive control points (PCP) with the builtin risk assessment models through the power of digital food safety plan.
Smart - Identity & Access Management (lAM) Software
Facilitate fast, safe, and compliance-ready user account management to secure access and manage all the internal and external users.
Smart - Laboratory Information Management System (LIMS) Software
Streamline laboratory process, increase workflow efficiency and improve employees and customer communications.
Smart - Food Safety and Recall Management Database Software
Stay on top of your supply chain risks by having access to commodity, country and Industry specific food safety recall information.